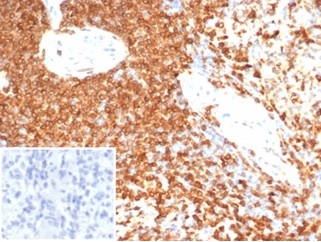

Formalin-fixed, paraffin-embedded human spleen stained with CD74 Mouse Monoclonal Antibody (CLIP/7193) at 2ug/ml. Inset: PBS instead of primary antibody; secondary only negative control.

Formalin-fixed, paraffin-embedded human spleen stained with CD74 Mouse Monoclonal Antibody (CLIP/7193) at 2ug/ml. HIER: Tris/EDTA, pH9.0, 45min. 2 °: HRP-polymer, 30min. DAB, 5min.
It recognizes a protein of ~35kDa, identified as CD74 (Workshop IV). CD74 is a type II transmembrane protein which binds to the peptide binding groove of newly synthesized MHC class II alpha/beta heterodimers and prevents their premature association with endogenous polypeptides. CD74 is expressed primarily by antigen presenting cells, such as B-lymphocytes (from before the pre-B cell stage to before the plasma cell stage), macrophages, and monocytes, and many epithelial cells. Anti-CD74 stains predominantly germinal center lymphocytes and B-cell lymphomas, but rarely T-cell lymphomas. Anti-CD74 has been shown to be useful in differentiating atypical fibroxanthoma (-) from malignant fibrous histiocytoma (+).
There are no reviews yet.